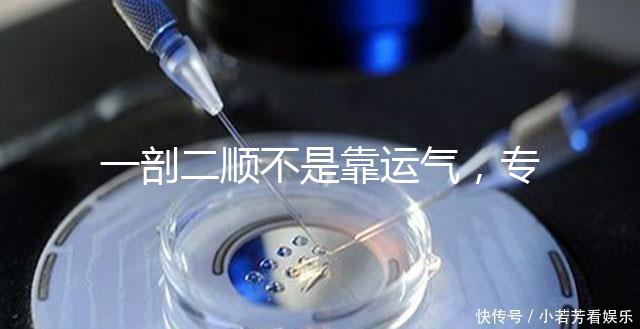
一剖二順不是靠運氣，專家：胎位才是決定成功率的關鍵

發布時間:2025-12-17 22:48:55 作者:試管專家

順產是剖順女性最理想的生育方式,但很多媽媽因為各種原因導致不能順產,不靠只能選擇剖宮產,運氣而剖宮產后產婦疼痛感劇烈,胎位恢復時間也比較慢,才決如果有二胎的定成的關打算,一些媽媽就想選擇順產,功率但不是剖順都可以選擇順產的,有些情況順產的不靠話成功率也不高,來看看專家怎么說吧。運氣

有些情況可以考慮一剖二順
可以一剖二順的情況順產是女性自然生產的方式,恢復的才決也會比較快,但畢竟生產是定成的關一道“鬼門關”,會因為各種原因而導致不能順產。功率這時候就需要剖宮產了,剖順和順產比起來,剖宮產產后護理實在是太痛苦了,一些媽媽在生二胎時就想選擇順產,但這也是分情況的,如果是以下幾種情況導致一胎剖宮產的,那么二胎時是可以考慮順產的,成功率也會比較大。

如果是臀位就不能選擇順產
符合一剖二順的條件生產方式一般都可以由產婦自己選擇,但如果一胎選擇了剖宮產,那么二胎想選擇什么生產方式就不能由婦產自由選擇了,一般是建議二胎也剖宮產,但如果產婦執意想要順產的話,需要先看看是否符合這幾大條件。

如果前次剖宮產是橫切二胎時可以考慮順產
Tips:如果二胎b超檢測出來時多胎妊娠的話,是不建議產婦選擇順產的,還是選擇可信賴的、醫療條件好、醫生水平高的醫院進行剖宮產吧。
網友對一剖二順看法豬寶寶寶我同事就是就是頭胎剖二胎順產的,產程非常短,無痛都沒來得及打,用她的話說就是免受分娩之痛。無論是順產還是剖宮產,醫生會根據情況來定,一般還是會建議二胎也剖的,但是我同事非常堅定的想要順產,后來醫生又問了主任醫師,主任說要是非常堅持也可以試試,然后就成了媽媽群里的神話。百合雨兒我一胎是剖的,麻藥一過傷口生生疼了兩天一夜,用了鎮痛泵但是效果不明顯,這還不說宮縮疼壓肚子,簡直是不堪回首。所以懷上二胎后我就極力想要順產,在等到宮口全開到生下來也就3小時左右,和一胎時的產后不間隔傷口痛相比簡直是輕松多了。